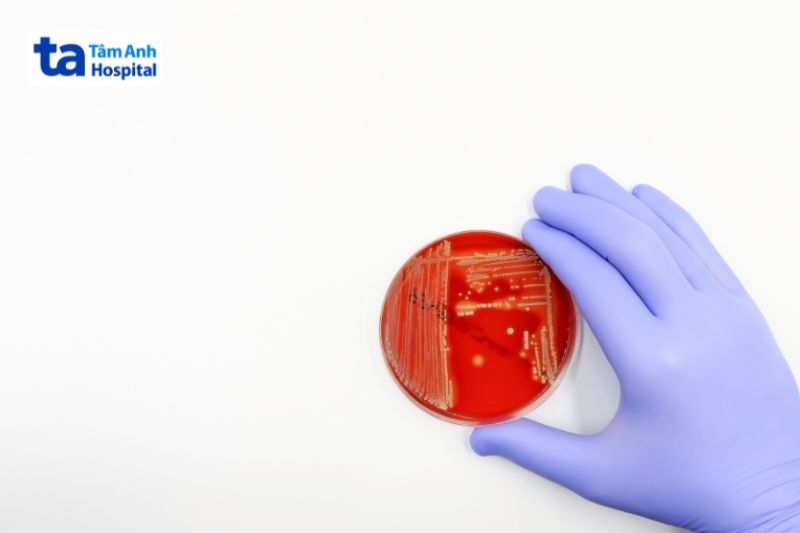

Xét nghiệm thương hàn hỗ trợ bác sĩ chẩn đoán bệnh thương hàn. Theo WHO, căn bệnh này khiến hơn 110.000 người tử vong mỗi năm trên toàn cầu (1). Vậy xét nghiệm bệnh này là gì, có bao nhiêu loại test? Hãy cùng Bệnh viện Đa khoa Tâm Anh theo dõi thông tin dưới đây.

Thương hàn là một bệnh nhiễm trùng đường ruột nghiêm trọng do vi khuẩn Salmonella Typhi gây ra. Người bệnh thường biểu hiện triệu chứng táo bón, sốt cao kéo dài, mệt mỏi, ho khan, phát ban quanh thắt lưng. Bệnh có xu hướng khởi phát đột ngột, tiến triển nặng thành hội chứng nhiễm độc toàn thân. Độc tố bệnh làm viêm cơ tim, trụy tim, viêm não, loét ruột, loét họng.
Thời gian vi khuẩn xâm nhập và ủ bệnh kéo dài 8-14 ngày. Việc xét nghiệm thương hàn sớm và kịp thời giúp bác sĩ điều trị hiệu quả, hạn chế nguy cơ gặp biến chứng nghiêm trọng, đe dọa tính mạng. Một số trường hợp sau cần ưu tiên làm xét nghiệm gồm: (2)

Các xét nghiệm thương hàn phổ biến, gồm:
Xét nghiệm Widal Salmonella là một trong những xét nghiệm huyết thanh lâu đời và phổ biến để tầm soát bệnh. Mục đích của xét nghiệm Widal là tìm kiếm kháng thể (Agglutinins) do cơ thể sản xuất để chống lại kháng nguyên O (Somatic) và kháng nguyên H (Flagellar) của vi khuẩn Salmonella Typhi.
Cấy máu là phương pháp nuôi cấy vi khuẩn từ mẫu máu của người bệnh trong môi trường phòng thí nghiệm. Đây được coi là “tiêu chuẩn vàng” trong việc chẩn đoán xác định bệnh. Từ kết quả cấy máu, bác sĩ không chỉ xác định được chủng vi khuẩn mà còn có thể thực hiện kháng sinh đồ. Kháng sinh đồ là một quy trình quan trọng giúp xác định loại kháng sinh nào hiệu quả nhất để tiêu diệt chủng vi khuẩn cụ thể, qua đó chọn ra phác đồ điều trị tối ưu, tránh được nguy cơ kháng thuốc.
Tương tự cấy máu, các phương pháp này nuôi cấy vi khuẩn từ mẫu bệnh phẩm khác của cơ thể như phân, tủy xương, nước tiểu để tìm kiếm sự hiện diện của Salmonella Typhi.
Kỹ thuật PCR (phản ứng chuỗi polymerase) là một phương pháp sinh học phân tử tiên tiến giúp khuếch đại và phát hiện vật chất di truyền (DNA) của vi khuẩn Salmonella Typhi từ các mẫu bệnh phẩm.
Kỹ thuật PCR cung cấp kết quả nhanh chóng, có độ chính xác rất cao, đặc biệt hữu ích trong giai đoạn đầu của bệnh – khi lượng vi khuẩn trong máu còn thấp hoặc khi các phương pháp khác chưa cho kết quả rõ ràng. Tuy nhiên, phương pháp này có chi phí cao hơn so với các xét nghiệm thông thường, đòi hỏi cơ sở y tế phải có thiết bị chuyên dụng và đội ngũ kỹ thuật viên được đào tạo chuyên sâu.

Việc đọc kết quả xét nghiệm thương hàn cần được thực hiện bởi bác sĩ. Trong tất cả các loại xét nghiệm được đề cập, kết quả dương tính với Salmonella typhi đồng nghĩa với việc người bệnh đã bị nhiễm bệnh và ngược lại.
Tuy nhiên, xét nghiệm Widal có thêm 2 thông số anti-H và anti-O. Anti-O là kháng thể chống lại kháng nguyên O của vi khuẩn Salmonella, thường xuất hiện sớm ở người nhiễm thương hàn cấp tính. Anti-H là kháng thể chống lại kháng nguyên H (lông vi khuẩn), xuất hiện muộn hơn và thường gặp ở người đã nhiễm hoặc từng tiêm vắc-xin.
Nếu chỉ số anti-H từ 1:160 trở lên hoặc anti-O từ 1:80 trở lên (thay đổi tùy từng vùng), người bệnh có dấu hiệu nghi ngờ nhiễm bệnh. Để chẩn đoán chính xác hơn, bác sĩ thường chỉ định người bệnh xét nghiệm lại sau 7-10 ngày, hoặc thực hiện đồng thời các xét nghiệm khác như cấy máu. Nếu xét nghiệm lặp lại cho thấy hiệu giá (nồng độ kháng thể) tăng tối thiểu 4 lần, đó chính là căn cứ chẩn đoán mắc bệnh thương hàn.
Nếu chỉ số anti-H nhỏ hơn 1:160 hoặc anti-O nhỏ hơn 1:80, kết quả này là bình thường, chưa đủ để chẩn đoán bệnh. Tuy nhiên cần lưu ý, kết quả âm tính của một xét nghiệm đơn lẻ không nên dùng để loại bỏ hoàn toàn chẩn đoán. Các tổ chức y tế khuyến cáo nên kết hợp nhiều phương pháp lại với nhau để giảm thiểu nguy cơ bỏ sót bệnh.
Quy trình xét nghiệm sốt thương hàn gồm nhiều bước, từ khâu chuẩn bị đến phân tích mẫu tại phòng xét nghiệm.
Bác sĩ tiến hành khai thác bệnh sử của mỗi người, tập trung vào triệu chứng lâm sàng, thuốc đang sử dụng, lịch sử tiêm vắc-xin thương hàn (nếu có).
Người bệnh được lấy mẫu máu tĩnh mạch theo quy trình vô khuẩn và chuyển đến phòng xét nghiệm để tiến hành phân tích. Tại đây, kỹ thuật viên sử dụng máy ly tâm để tách huyết thanh khỏi các thành phần còn lại của máu. Huyết thanh sau đó được nhỏ lên phiến kính hoặc cho vào ống nghiệm, rồi trộn với kháng nguyên đặc hiệu. Việc xuất hiện các hạt kết tụ (ngưng kết) trong hỗn hợp chính là căn cứ đánh giá sự hiện diện của kháng thể chống lại Salmonella Typhi, qua đó hỗ trợ bác sĩ chẩn đoán bệnh.
Điều dưỡng sát khuẩn da vùng lấy máu bằng cồn hoặc dung dịch sát khuẩn chuyên dụng trong tối thiểu 30 giây và để khô hoàn toàn trước khi chọc kim. Mẫu máu sẽ được đưa vào các chai cấy chuyên dụng. Đối với người lớn, cần lấy tối thiểu 8-10 mL máu mỗi chai để đảm bảo có đủ lượng vi khuẩn. Mẫu máu nên được lấy trước khi người bệnh sử dụng thuốc kháng sinh do kháng sinh có thể gây ức chế sự phát triển của vi khuẩn, dẫn đến kết quả âm tính giả.
Mẫu cấy máu cần được nuôi cấy trong vòng vài giờ sau khi lấy để vi khuẩn không bị chết hoặc suy yếu. Nếu nghi ngờ người bệnh có nguy cơ nhiễm bệnh cao nhưng kết quả ban đầu âm tính, cần lấy thêm khoảng 2 đến 4 mẫu, mỗi mẫu cách nhau 30 phút đến 1 giờ hoặc lấy vào ngày kế tiếp.
Việc lấy mẫu phân hoặc nước tiểu thường được chỉ định trong giai đoạn sau bệnh. Mẫu phân tươi và nước tiểu trong ngày được thu thập cho vào một bình vô trùng. Nếu không thể gửi ngay đến phòng xét nghiệm, phân và nước tiểu sẽ được bảo quản lạnh để duy trì tính toàn vẹn của mẫu bệnh phẩm.

Một số lưu ý quan trọng mà người bệnh cần ghi nhớ trong quá trình xét nghiệm bao gồm:
Dưới đây là một số câu hỏi thường gặp liên quan đến xét nghiệm thương hàn:
Xét nghiệm bằng phương pháp cấy máu, cấy phân, test Widal không yêu cầu nhịn ăn. Người bệnh có thể ăn uống bình thường trước khi lấy mẫu mà không ảnh hưởng đến kết quả.
Một số nơi có bán bộ kit test Widal đơn giản nhưng các que thử nhanh huyết thanh hoặc huyết tương này có thể cho kết quả chính xác không cao. Các chuyên gia khuyến cáo chỉ dùng kết quả test Widal nhanh để sàng lọc ban đầu. Khẳng định chẩn đoán phải dựa vào quá trình cấy khuẩn hoặc các loại xét nghiệm chuyên sâu khác. (3)

Chi phí xét nghiệm thương hàn bao nhiêu tiền còn tùy vào từng cơ sở y tế và phương pháp xét nghiệm được ứng dụng. Xét nghiệm Widal thường có giá từ 250.000 VNĐ trở lên. Tuy nhiên, mức giá này chỉ mang tính tham khảo và thay đổi theo thời gian. Người bệnh nên tham khảo bảng giá hoặc liên hệ với bệnh viện để được tư vấn ngay tại thời điểm có nhu cầu.
Xét nghiệm chẩn đoán bệnh nên được thực hiện tại cơ sở y tế uy tín, có hệ thống phòng xét nghiệm vi sinh đạt chuẩn, được vận hành bởi đội ngũ bác sĩ, kỹ thuật viên giàu kinh nghiệm, đơn cử như Hệ thống Bệnh viện Đa khoa Tâm Anh TP.HCM. Bệnh viện còn có sự phối hợp hội chẩn đa chuyên khoa, giúp cá nhân hóa kế hoạch điều trị, đem lại kết quả tối ưu cho từng người bệnh.
HỆ THỐNG BỆNH VIỆN ĐA KHOA TÂM ANH
Bài viết cung cấp một số thông tin cơ bản về các phương pháp xét nghiệm thương hàn. Đây là căn bệnh nguy hiểm với tỷ lệ tử vong cao tới 10-20%. Song, nếu được chẩn đoán, điều trị kịp thời, tỷ lệ này giảm xuống dưới 1%. Người thuộc nhóm đối tượng có nguy cơ cao như: sống trong khu vực thiếu nước sạch, vệ sinh kém, người cao tuổi, trẻ em dưới 5 tuổi, người bị suy giảm hệ miễn dịch… nếu có dấu hiệu nghi ngờ, cần được xét nghiệm, chẩn đoán, điều trị sớm.